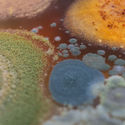
More from the 2021 Venice Architecture Biennale Exhibitions - Image 10 of 31

The 17th Venice Architecture Biennale invited architects to ponder the question “How will we live together”, eliciting various answers and interpretations. The International Exhibition unfolding in Giardini, the Arsenale and Forte Maghera presents 113 participants in the competition, coming from 46 countries, whose contributions are organized into five scales: Among Diverse Beings, As New Households, As Emerging Communities, Across Borders, and As One Planet. The following participants explore a variety of subjects, prompting a holistic re-evaluation of the collective in relationship with issues ranging from the urban and natural environment to climate action or the relationship with other species.
Antarctic Resolution
Giulia Foscari / Unless

Representing 10% of the landmass, Antarctica is at the same time a contested territory, an indispensable resource and a crucial scientific field of exploration. Antarctic Resolution, created by Giulia Foscari / Unless, is a multidisciplinary project co-authored by world-renowned experts painting a comprehensive picture of the continent’s geography, conditions and geopolitical significance. The exhibition presents this holistic body of research on Antarctica, accompanied by Antarctic suits and an evocative soundscape.
The Planet After Geoengineering

Exploring the concept of geoengineering, Design Earth’s contribution to the biennial brings abstract climate models to public debate through visualization. Five stories, each following the deployment of a specific technique, explore climate engineering and its controversies in a cautionary speculative narrative that raises questions regarding human intervention in Earth’s systems. The exhibition aims to highlight the role of design in climate communication to explain the severity of the climate crisis.
Entangled Kingdoms

The Greek practice Doxiadis+ brings to focus the intricate web of lifeforms and processes on Earth by presenting visitors with a “garden” of fungi, cultivated from the spores within the Arsenale rooms and grown in the mycology department at the University of Athens. The installation invites reflection on the complexity and importance of this kingdom, capable of metabolizing and decomposing organic matter, thus facilitating life on Earth.
Playscapes of Exile

Exploring the refugee camps housing Syrians and Palestinians in Lebanon, architect and photographer Wissam Chaaya highlights the improvised playscapes of refugee children in an environment characterized by a scarcity of space and resources. The photographic essay on display at the Biennale captures an altered way of “living together” where various activities take place spontaneously in improvised areas around the camps, showcasing children at the forefront of this space quest.
Alive: A New Spatial Contract for Multispecies Architecture

Exploring the idea of probiotic and multispecies architecture, the installation uses a textured and porous organic material to create a space with various microclimates which could foster different types of microbes. Building on the premise that harmful organisms are mitigated by benign ones within a diverse microbial life, the installation proposes a prototype for a new spatial contract and vision for the future where architectural environments foster microbial diversity, thus contributing to collective health.
Beirut Shifting Grounds
Sandra Frem and Boulos Douaihy in collaboration with Carla Aramouny, Rana Haddad and Nicolas Fayad

Highlighting the bottom-up mobilization in Beirut following various challenges, from economic struggles to the port explosion, the project explores different ways of re-appropriating the city. Highlighting spatial practices of reclamation, improvisation and production, Beirut Shifting Grounds speculates on different ways of engaging collective energies and local realities to catalyze a series of bottom-up, community-oriented projects on various sites throughout the city.
Future Assembly

The result of a collaboration between six co-designers and fifty Biennale participants, the Future Assembly exhibition highlights the living and non-living entities left out from human legislation, drawing attention to the need to secure the rights of nature. From fungi to estuaries, the stakeholders are gathered on a circular carpet woven from ocean plastic, echoing the United Nations Assembly. Featuring a history of human‘s attempts to secure the integrity of nature, the project highlights the interdependency of species, elements and systems.
We invite you to check out ArchDaily's comprehensive coverage of the Venice Architecture Biennale 2021, and watch our official playlist on Youtube featuring exclusive interviews with architects and curators of the Biennale.